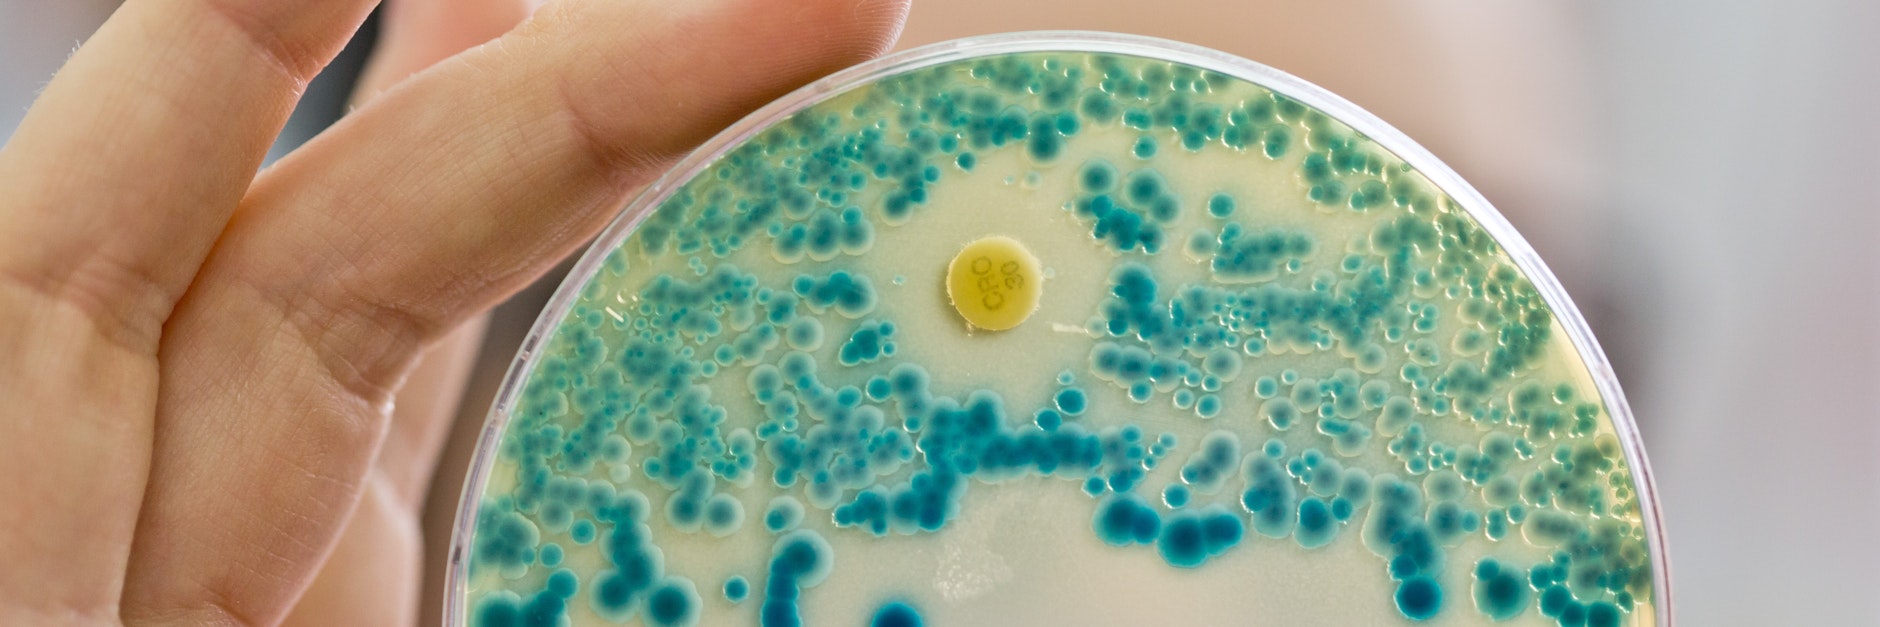
Resistente Keime - weltweit sterben jedes Jahr 700.000 Menschen wegen dieser Erreger.

AMR – hinter diesen drei Buchstaben verbirgt sich die Gefahr, die jedes Jahr weltweit 700.000 Menschen das Leben kostet: Antibiotika-Resistenzen. Bis 2050 könnte die Zahl der Todesopfer wegen resistenter Keime im schlimmsten Fall auf jährlich zehn Millionen Menschen steigen und damit die gegenwärtige Corona-Krise völlig in den Schatten stellen. „AMR ist ein langsamer Tsunami, der ein Jahrhundert des medizinischen Fortschritts zunichte zu machen droht“, warnte der Generaldirektor der Weltgesundheitsorganisation WHO, Tedros Adhanom Ghebreyesus.

Mehr als 20 führende Arzneimittelhersteller wollen sich nun für die Entwicklung neuer Antibiotika zusammenschließen. Dafür setzen sie einen Fonds über eine Milliarde Dollar zur Finanzierung der Forschung auf, wie der weltweite Pharmaverband IFPMA mitteilt. Bis 2030 soll so die Entwicklung von zwei bis vier neuartigen Antibiotika ermöglicht werden. „Wenn Staaten, Wirtschaft und Wissenschaft die Kräfte bündeln, dann machen wir einen Unterschied“, sagte Gesundheitsminister Jens Spahn bei einem Treffen zur Vorstellung des Verbands in Berlin.
Antibiotika-Entwicklung bringt keinen Profit
Rund 20 Jahre ist es her, dass die bislang letzte komplett neue Klasse von Antibiotika auf den Markt kam. Dabei nehmen weltweit Resistenzen gegen Antibiotika in bedrohlichem Ausmaß zu. Doch seit Jahren wird dieses Forschungsfeld von der Pharmaindustrie stiefmütterlich behandelt. Die großen Konzerne haben sich aus einem schlichten Grund zurückgezogen: Mit Antibiotika, die nur für wenige Tage verschrieben werden und möglichst selten zur Anwendung kommen sollen, um neue Resistenzen zu vermeiden, ist kein Profit zu machen. Um dies zu ändern, müssten speziell für Antibiotika andere Bezahlmodelle gelten, wie etwa eine Jahrespauschale für die Hersteller.
Nun soll eine der größten gemeinsamen Initiativen, die je von der pharmazeutischen Industrie unternommen wurde, die drohende Katastrophe verhindern. Unterstützung für den neuen Fonds kommt unter anderem von Pharmariesen wie Pfizer, Roche, Novartis und GlaxoSmithKline sowie den deutschen Unternehmen Bayer, Boehringer Ingelheim und Merck. Auch die Weltgesundheitsorganisation WHO und die Europäische Investitionsbank (EIB) sind mit im Boot.

„Im Gegensatz zu Covid-19 ist AMR eine vorhersehbare und vermeidbare Krise. Wir müssen gemeinsam handeln, um die Antibiotika-Pipeline wieder aufzubauen“, erklärt Thomas Cueni, Generaldirektor des Pharmaverbands IFPMA. Mit den Geldern aus dem Fonds sollen die schwierigsten Phasen der Arzneimittelentwicklung unterstützt werden, er soll voraussichtlich ab dem vierten Quartal 2020 einsatzbereit sein. Ein unabhängiges Forscher-Gremium soll Empfehlungen machen, an wen das Geld geht.